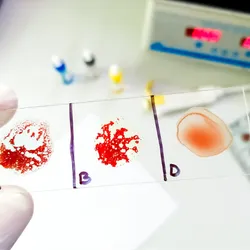
A gloved hand holding a slide containing an agglutination test for AB negative rare blood group.

Explainer
Trending

The Ear as a Therapeutic Gateway to the Vagus Nerve
Auricular vagal neuromodulation therapy is a non-invasive and non-surgical treatment that could aid cardiovascular disease management, Long COVID relief, and more.

Universe 25 Experiment
A series of rodent experiments showed that even with abundant food and water, personal space is essential to prevent societal collapse, but Universe 25's relevance to humans remains disputed.

T Cell Nomenclature Gets an Update
Improved technologies have allowed researchers to delve deeper into T cell biology, but the traditional naming scheme has struggled to keep up with new findings.

Freeze-Tolerant Frogs Power Organ Cryopreservation Strategies
Frogs that freeze themselves solid in the winter and thaw in the spring inspired methods to extend the storage time for transplantable organs.
Multimedia

Skip the Wait for Protein Stability Data with Aunty
In this webinar, Andre Mueller will discuss how scientists characterize therapeutic proteins in different formulations and spot the effects of excipients on protein stability.


Thermo Scientific X and S Series General Purpose Centrifuges
Thermo Scientific X and S Series General Purpose Centrifuges are designed to help provide exceptional performance, versatility and enhanced sustainability.